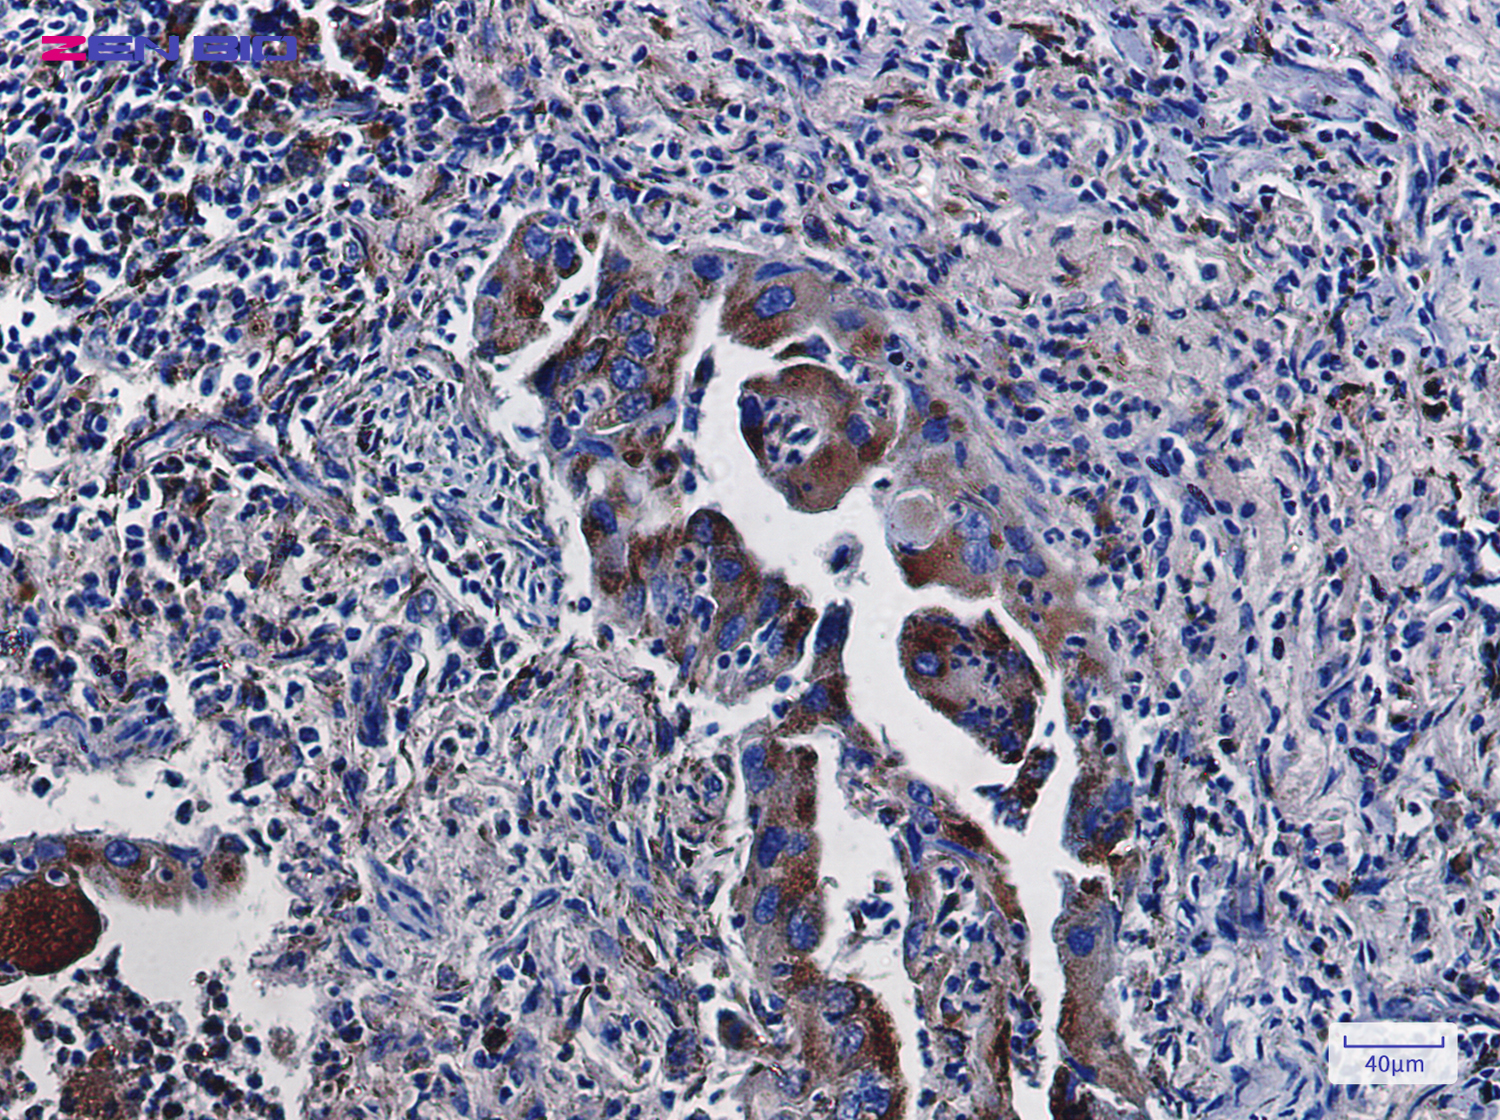
Immunohistochemistry of LAMP2 in paraffin-embedded Human lung cancer tissue using LAMP2 Rabbit pAb at dilution 1/100

-
Product Name
Anti-LAMP2 Rabbit antibody
- Documents
-
Description
LAMP2 Rabbit polyclonal antibody
-
Tested applications
WB, IHC-P
-
Species reactivity
Human
-
Isotype
Rabbit IgG
-
Preparation
Antigen: A synthetic peptide of human LAMP2
-
Clonality
Polyclonal
-
Formulation
Supplied in 50nM Tris-Glycine(pH 7.4), 0.15M Nacl, 40%Glycerol, 0.01% sodium azide and 0.05% BSA.
-
Storage instructions
Store at -20°C. Stable for 12 months from date of receipt.
-
Applications
WB: 1/1000
IHC: 1/200
-
Validations
Immunohistochemistry of LAMP2 in paraffin-embedded Human lung cancer tissue using LAMP2 Rabbit pAb at dilution 1/100

Western blot detection of LAMP2 in THP-1 cell lysates using LAMP2 Rabbit pAb(1:1000 diluted).Predicted band size:45KDa.Observed band size:110KDa.
-
Background
Swiss-Prot Acc.P13473.Plays an important role in chaperone-mediated autophagy, a process that mediates lysosomal degradation of proteins in response to various stresses and as part of the normal turnover of proteins with a long biological half-live (PubMed:8662539, PubMed:11082038, PubMed:18644871, PubMed:24880125, PubMed:27628032). Functions by binding target proteins, such as GAPDH and MLLT11, and targeting them for lysosomal degradation (PubMed:8662539, PubMed:11082038, PubMed:18644871, PubMed:24880125). Plays a role in lysosomal protein degradation in response to starvation . Required for the fusion of autophagosomes with lysosomes during autophagy (PubMed:27628032). Cells that lack LAMP2 express normal levels of VAMP8, but fail to accumulate STX17 on autophagosomes, which is the most likely explanation for the lack of fusion between autophagosomes and lysosomes (PubMed:27628032). Required for normal degradation of the contents of autophagosomes (PubMed:27628032). Required for efficient MHCII-mediated presentation of exogenous antigens via its function in lysosomal protein degradation; antigenic peptides generated by proteases in the endosomal/lysosomal compartment are captured by nascent MHCII subunits (PubMed:20518820). Is not required for efficient MHCII-mediated presentation of endogenous antigens (PubMed:20518820).
Related Products / Services
Please note: All products are "FOR RESEARCH USE ONLY AND ARE NOT INTENDED FOR DIAGNOSTIC OR THERAPEUTIC USE"
